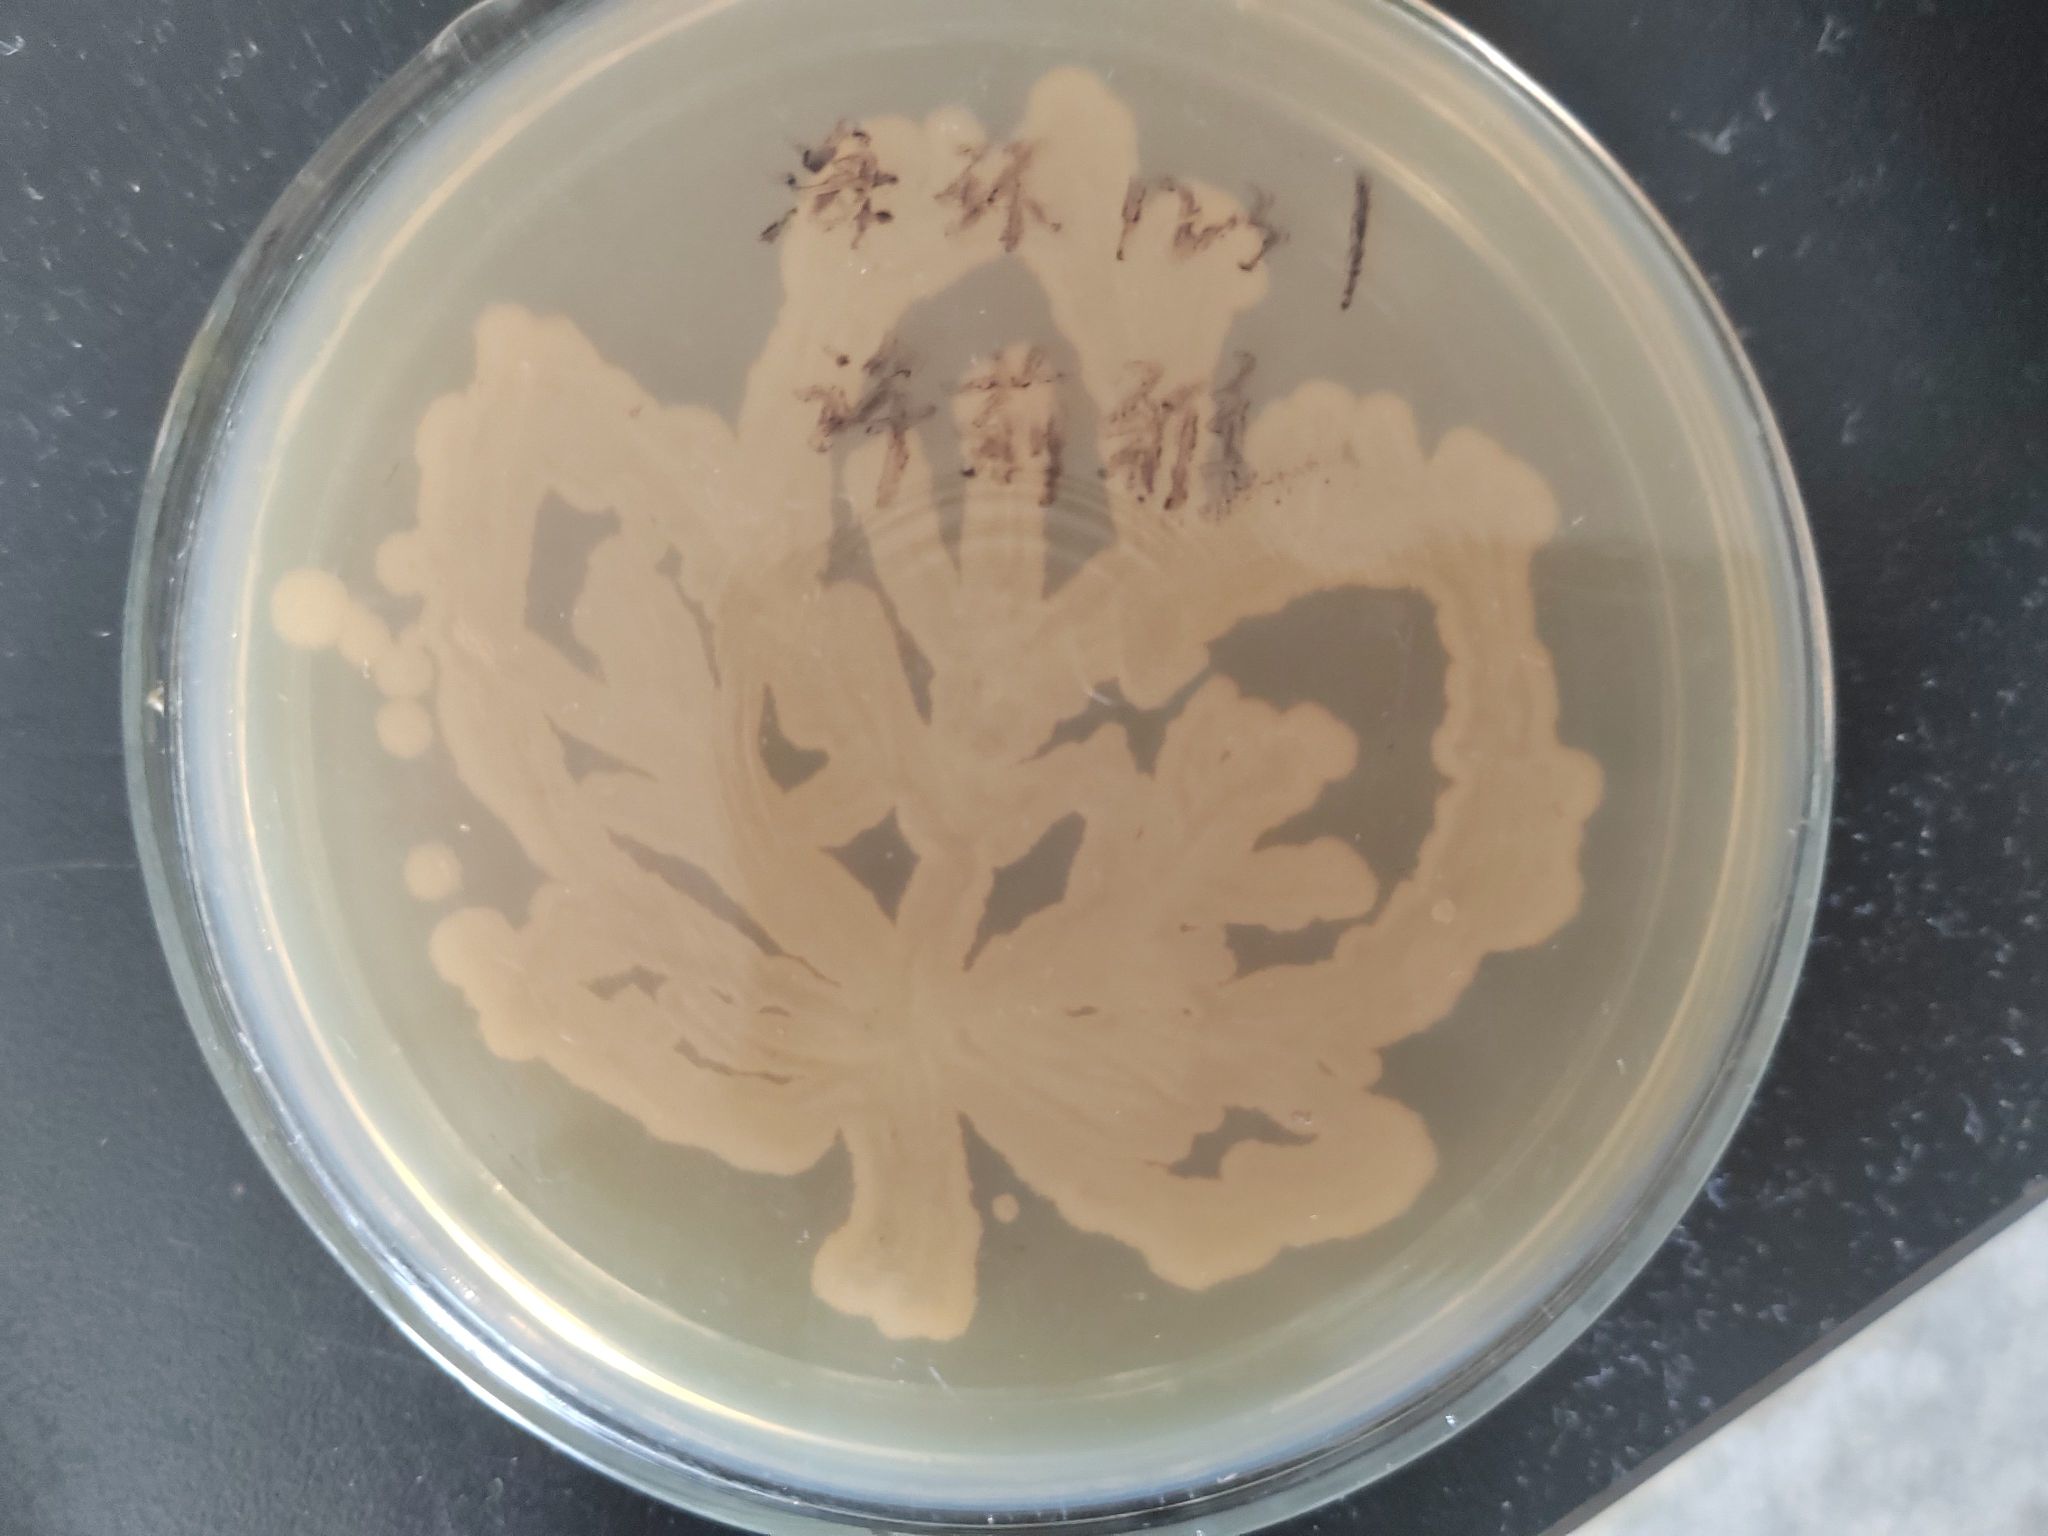

5月12日下午,生命-海洋协会在苍梧校区海洋楼301/302实验室成功举办微生物平板划线大赛。本次活动面向羞羞漫画
全体学生。本次活动主题为“作纵横交错,见微观之美”,旨在为学生提供一个综合发展的平台,学习了解微生物知识以及相关实验操作,活动受到热烈欢迎,110余人报名参加了本次活动。
本次活动共分为三个阶段。第一阶段为4月19日至4月23日,社团工作人员进行材料准备和活动前期宣传;第二阶段为4月24日至4月30日,报名参加活动的同学进行线上考试,由协会工作人员根据答卷情况筛选参与决赛的选手;第三阶段则是实验室实操活动。在平板划线活动正式开始前,会长孙尧核对参与人员名单,组织社团成员发放实验用具,详细指导实验流程和注意事项。全体同学认真听讲并表示充分理解了讲解的注意要点,在讲解结束后有序开展平板划线活动。
随着主持人宣布比赛开始,选手们立刻聚精会神地投入到比赛当中,在工作人员的指导下,创作出各式各样极具创造性、图案精美的作品,大家在完成实验后上交了培养皿和实验材料。
活动最后,孙尧对活动进行了总结及点评。工作人员认真清理实验用具并整理实验室。后期,活动组织方会将选手作品放入恒温箱中培养,并对最终作品进行打分,评选出优秀作品。
本次微生物平板划线大赛的成功举办,激发了同学们对艺术与生物的兴趣和热爱,提供了多学科融合的平台,帮助同学们了解微生物知识、提高艺术修养。